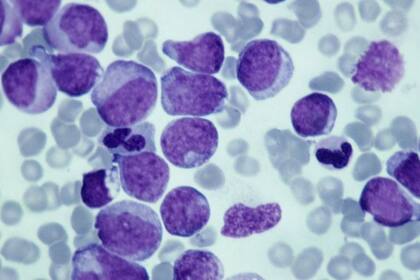
Desde un punto de vista evolutivo, hay hipótesis que pueden explicar la aparición del cáncer y la similitud de sus atributos

Se trata de una enfermedad ancestral relacionada con la aparición de los metazoos, animales compuestos de varias células, en oposición a los protozoos que están constituidos por una sola célula, hace más de quinientos millones de años
13 minutos de lectura'
El cáncer plantea multitud de cuestiones a los biólogos, gran parte de ellas todavía sin terminar de resolver. ¿Cómo se explican los orígenes de esta enfermedad? ¿Por qué es tan difícil de curar? ¿Por qué persiste la vulnerabilidad al cáncer en la mayoría de los organismos pluricelulares?
Los enfoques basados en la explicación de los mecanismos de esta enfermedad y las investigaciones clínicas no son suficientes frente a estos interrogantes.
Debemos observar el cáncer desde una nueva perspectiva, adoptando una visión evolutiva. En otras palabras, debemos mirar el cáncer a través de los ojos de Charles Darwin, padre de la teoría de la evolución.
Desde hace unos años, el esfuerzo conjunto de biólogos evolutivos y oncólogos está fomentando reflexiones que se traducen en avances transversales beneficiosos para ambas disciplinas, a la vez que cambian nuestra comprensión de la enfermedad.
Cómo la evolución de los organismos pluricelulares prepara el terreno para el cáncer

El cáncer afecta al conjunto del reino animal pluricelular. La razón es que se trata de una enfermedad ancestral relacionada con la aparición de los metazoos (animales compuestos de varias células, en oposición a los protozoos que están constituidos por una sola célula), hace más de quinientos millones de años.
La aparición de tales organismos complejos requirió el desarrollo de altos niveles de cooperación entre la multitud de células que los componen.
En efecto, esa cooperación se sostiene por comportamientos complementarios y altruistas, en particular por la apoptosis o suicidio celular (por el cual una célula activa su autodestrucción al recibir una cierta señal) y por la renuncia a la reproducción directa por parte de toda célula que no sea una célula sexual.
Es decir, la evolución hacia entes pluricelulares estables se produjo por la selección de adaptaciones que, por un lado, facilitaban el funcionamiento colectivo y, por otro lado, reprimían los reflejos unicelulares ancestrales.
El cáncer representa una ruptura de esa cooperación pluricelular, seguida de la adquisición de adaptaciones que permiten que esas células “renegadas” se perfeccionen en su propio modo de vida.
Dicho de otra forma, las células malignas comienzan a “hacer trampas”.
Pueden hacerlo pues han sufrido mutaciones genéticas (modificaciones de la secuencia de genes) o epigenéticas (modificaciones que cambian la expresión de los genes y que, además de transmisibles, son reversibles, al contrario de las mutaciones genéticas), o incluso las dos, lo que les confiere un valor selectivo más alto en comparación con las células de comportamiento cooperativo.

Puede consistir, por ejemplo, en ventajas de crecimiento, de multiplicación, etc.
De la misma forma, es imperativo que las células portadoras de esas modificaciones se sitúen en un microentorno favorable a su proliferación.
Si estas “rebeliones celulares” no son reprimidas de manera correcta por los sistemas de defensas del organismo (como el sistema inmunitario), la abundancia de células cancerosas puede aumentar localmente.
Consecuencias: los recursos se agotan y estas células pueden iniciar entonces comportamientos individuales o colectivos de dispersión y de colonización hacia nuevos órganos, las tristemente conocidas metástasis responsables de la mayoría de los decesos debidos al cáncer.
De ese modo, en unos meses o años, una sola célula cancerosa puede generar un “ecosistema” complejo y estructurado, el tumor sólido (comparable a un órgano funcional), así como metástasis más o menos diseminadas por el organismo.
Un aspecto intrigante de esta enfermedad reside en el número significativo de semejanzas entre los atributos de las células cancerosas provenientes de diferentes órganos, individuos e incluso especies, lo que sugiere que los procesos que tienen lugar en cada caso son similares.
Sin embargo, cada cáncer evoluciona como una nueva entidad, ya que, aparte de los cánceres transmisibles antes mencionados, los tumores desaparecen siempre junto a sus huéspedes, sin transmitir sus innovaciones genéticas ni fenotípicas.
Entonces, ¿cómo se explican esas semejanzas?
Persistencia del cáncer a lo largo del tiempo evolutivo
Desde un punto de vista evolutivo, hay dos hipótesis que pueden explicar la aparición del cáncer y la similitud de sus atributos.
La teoría del atavismo explica el cáncer como un retorno a capacidades anteriores de las células, entre las que se encuentra la liberación de un programa de supervivencia excelentemente conservado, siempre presente en toda célula eucariota y, por tanto, en todo organismo pluricelular.
Se cree que la selección de este programa ancestral tuvo lugar durante el período precámbrico, que comenzó hace 4.550 millones de años y terminó hace 540 millones de años.
Durante este período, que vio surgir la vida sobre nuestro planeta, las condiciones medioambientales eran muy distintas de las actuales y, a menudo, desfavorables.
Las fuerzas selectivas que actuaban sobre los organismos unicelulares favorecieron las adaptaciones para la proliferación celular.
Algunas de esas adaptaciones, seleccionadas a lo largo de la vida unicelular, quedaron presentes para siempre, más o menos escondidas en nuestros genomas.
Cuando su expresión escapa de los mecanismos de control, comienza una lucha entre los rasgos ancestrales unicelulares y los rasgos pluricelulares actuales y es entonces cuando puede aparecer un cáncer.

Es más, esta hipótesis podría explicar también por qué las células cancerosas se adaptan tan bien a los entornos ácidos y pobres en oxígeno (anóxicos), pues estas condiciones eran habituales en el Precámbrico.
La segunda hipótesis implica un proceso de selección somático -las células somáticas agrupan la totalidad de las células de un organismo a excepción de las células sexuales- que conduce a una evolución convergente, es decir, a la aparición de rasgos análogos.
Esta hipótesis sugiere que la aparición de los rasgos celulares que caracterizan las células “tramposas” se somete a una fuerte selección cada vez que aparece un nuevo tumor, con independencia de cuáles sean las causas inmediatas de dichos rasgos.
Estos procesos de selección somática, al tener lugar en entornos regidos en gran medida por los mismos condicionantes ecológicos (como los que reinan en el interior de los organismos pluricelulares), darían lugar a una evolución convergente.
Eso podría explicar las similitudes que observamos a través de la diversidad del cáncer. No olvidemos que solo vemos los cánceres que consiguen desarrollarse, pero no sabemos cuántos “candidatos” fracasan al no conseguir adquirir las adaptaciones necesarias en el momento adecuado.
Estas dos hipótesis no son excluyentes: la reaparición de un programa ancestral puede estar seguida de una selección somática que culmine en una evolución convergente.
Cualquiera que sea la razón del origen del cáncer, hay una pregunta que sigue sin respuesta: si esta enfermedad suele causar la muerte del huésped, ¿por qué no ha sido más eficaz la selección natural en conseguir que los organismos pluricelulares sean completamente resistentes al cáncer?
Los animales grandes no tienen más cáncer

Los mecanismos de supresión del cáncer son numerosos y complejos. Cada división celular puede provocar mutaciones somáticas que alteren los mecanismos genéticos que controlan la proliferación celular, la reparación del ADN o la apoptosis, perturbando así el control del proceso de formación del cáncer (carcinogénesis).
Si cada división celular conlleva una probabilidad dada de que se produzca una mutación cancerígena, entonces, el riesgo de desarrollar un cáncer debería ser función del número de divisiones celulares a lo largo de la vida de un organismo.
Sin embargo, las especies de gran tamaño y más longevas no tienen más cáncer que aquellas pequeñas que viven menos tiempo.
En las poblaciones naturales animales, la frecuencia del cáncer varía, en general, entre un 0% y un 40 % para todas las especies estudiadas y no existe relación con la masa corporal.
En los elefantes y en los ratones se observan niveles de prevalencia del cáncer bastante similares, a pesar de que los elefantes desarrollen muchas más divisiones celulares a lo largo de su vida que los ratones.
Este fenómeno se conoce como “la paradoja de Peto”.
La explicación de esta paradoja reside en el hecho de que las fuerzas evolutivas han seleccionado mecanismos de defensa más eficaces en los animales grandes que en los pequeños, lo que permite reducir el lastre ligado al cáncer por el aumento de tamaño.
Por ejemplo, los elefantes tienen veinte copias del gen supresor de tumores TP53, mientras que los humanos solo disponemos de dos.
Encontramos excepciones notables a esta tendencia general, como es el caso de especies de pequeño tamaño con una longevidad fuera de lo normal. Estas especies tampoco desarrollan apenas cáncer.
Un buen ejemplo es el de la rata topo desnuda (Heterocephalus glaber), una especie cuyos individuos viven mucho tiempo (especie longeva) y no desarrollan tumores espontáneos, con la excepción de algunos casos de cáncer detectados de forma anecdótica.
Una enfermedad que se manifiesta de forma tardía

Recordemos también que la eficacia de las defensas contra el cáncer experimenta una disminución una vez que los organismos han llevado a cabo lo esencial de su reproducción, ya que las presiones evolutivas son menores en esta etapa de la vida.
Esta pérdida de eficacia, junto con la acumulación de mutaciones a lo largo del tiempo, explica que la mayor parte de los cánceres (mama, próstata, pulmón, páncreas…) aparezcan en la segunda mitad de la vida.
Una de las implicaciones evolutivas capitales es que si, desde una perspectiva darwiniana, el cáncer no es una preocupación relevante cuando se manifiesta tras la fase reproductiva, eso significa también que nuestras defensas se habrán optimizado por selección natural no para erradicar de forma sistemática los procesos oncogénicos sino para controlarlos mientras tengamos capacidad reproductora
Al final, esas defensas low cost, cuyo objetivo es resistir frente a los tumores, se revelan más ventajosas para salvaguardar el éxito reproductor que como estrategias de erradicación sistemática, que serían sin duda mucho más costosas.
El sistema inmunitario, por ejemplo, no trabaja a cambio de nada…
En general, los seres vivos se rigen por soluciones de compromiso, trade-offs en inglés, que hacen que toda inversión en una función necesite de una serie de recursos y energía que ya no estarán disponibles para otras funciones.
Nuestras defensas contra las enfermedades, el cáncer incluido, no quedan fuera de esta regla de funcionamiento.
Por desgracia, esas defensas low cost contra el cáncer se convierten al final en bombas con retardo… En otras palabras, ¡la lógica darwiniana no nos lleva siempre a resultados que casen con nuestras expectativas como sociedad en términos de salud!
Aunque la mayor parte de las mutaciones cancerígenas se producen en células somáticas a lo largo de la vida, hay casos raros de cáncer cuya causa se encuentra en mutaciones hereditarias en la línea germinal, la que produce las células sexuales.
Esas mutaciones congénitas, a veces, son más frecuentes de lo que se esperaría del equilibrio mutación-selección.
Esta paradoja se puede explicar por diversos procesos evolutivos. Por ejemplo, se ha sugerido que, probablemente, la selección natural no actuará sobre esas mutaciones si, una vez más, sus efectos negativos sobre la salud solo se manifiestan cuando haya terminado el período reproductivo.
Por otro lado, se podría recurrir a la teoría de la pleiotropía antagonista. Esta teoría estipula que ciertos genes tienen efectos contrarios sobre la probabilidad de supervivencia /reproducción según la edad considerada: sus efectos serían positivos al comienzo de la vida y negativos en el resto.
Si el efecto positivo inicial es notable, es posible que la selección retenga esa variante genética aunque cause una enfermedad mortal más tarde.
Por ejemplo, las mujeres que presentan una mutación de los genes BRCA1 y BRCA2 tienen un riesgo significativamente más alto de desarrollar cánceres de mama o de ovario, pero esas mutaciones parecen estar relacionadas con una mayor fertilidad.
Implicaciones en materia de tratamientos

El cáncer, auténtico lastre de las poblaciones humanas, es ante todo un fenómeno regido por procesos evolutivos, desde su origen en la historia de la vida hasta su desarrollo en tiempo real en una persona enferma.
La separación tradicional entre oncología y biología evolutiva, por tanto, debe desaparecer, pues limita nuestra comprensión de la complejidad de los procesos que culminan en la manifestación de la enfermedad.
Esta nueva perspectiva del cáncer podría resultar útil para el desarrollo de soluciones terapéuticas innovadoras que limiten los problemas asociados a las estrategias de tratamiento disponibles en la actualidad.
Estas terapias de altas dosis, que buscan matar el máximo de células malignas, acaban provocando a menudo la proliferación de células resistentes. A la inversa, la terapia adaptativa, profundamente enraizada en la biología evolutiva, podría constituir un enfoque alternativo.
Esta estrategia consiste en disminuir la presión que conllevan las terapias de altas dosis con el fin de eliminar solo una parte de las células cancerosas sensibles.
Se trata de mantener un nivel suficiente de competición entre las células cancerosas sensibles y las células cancerosas resistentes, con el fin de evitar o de limitar la proliferación sin restricciones de las resistentes.
Una problemática que no se limita al ser humano

Hasta hace poco, rara vez la oncología había adoptado los conceptos de la biología evolutiva para mejorar la comprensión de los procesos malignos.
De igual forma, los ambientalistas y los biólogos evolutivos apenas se han interesado en la existencia de estos fenómenos en sus investigaciones sobre los seres vivos.
Pero las cosas cambian y la consideración del cáncer -o, más bien, de los procesos oncogénicos en su conjunto- en el seno de la fauna salvaje suscita un entusiasmo creciente en el seno de la comunidad de los ambientalistas y de los biólogos evolutivos.
En efecto, a día de hoy, el cáncer se muestra con claridad como un modelo biológico pertinente para estudiar la evolución de los seres vivos, así como un fenómeno biológico de importancia para comprender diversas facetas de la ecología de las especies animales y sus consecuencias sobre el funcionamiento de los ecosistemas.
Aunque no siempre evolucionen hacia formas invasivas o metastásicas, los procesos tumorales son omnipresentes en los metazoos y hay estudios teóricos que sugieren que, probablemente, en estos últimos tengan influencia en variables fundamentales en ecología, como son los rasgos de historia de la vida, las aptitudes competitivas, la vulnerabilidad a los parásitos y a los depredadores, o incluso la capacidad de dispersarse.
Esos efectos provienen tanto de consecuencias patológicas de los tumores como de los costes asociados al funcionamiento de los mecanismos de defensa de los huéspedes.
La comprensión de las consecuencias ecológicas y evolutivas de las interacciones huésped-tumor se ha vuelto también un tema de investigación de referencia en ecología y en biología evolutiva en estos últimos años.
Estos cuestionamientos científicos son todavía más pertinentes cuando la práctica totalidad de los ecosistemas del planeta, sobre todo los medios acuáticos, está contaminada hoy en día por sustancias de origen antrópico y, a menudo, mutágenicas.
Por lo tanto, es primordial mejorar la comprensión de las interacciones huésped-tumor y sus efectos en cascada dentro de las comunidades, para así predecir y anticipar las consecuencias de las actividades humanas en el funcionamiento de los ecosistemas y en el mantenimiento de la biodiversidad.
Artículo traducido gracias a la colaboración con Fundación Lilly.
*Audrey Arnal es Post-doctorante, en el laboratorio MIVEGEC (UMR IRD 224-CNRS 5290-Université de Montpellier), Institut de recherche pour le développement (IRD)
Benjamin Roche es Director de Investigación del Institut de recherche pour le développement (IRD)
Frédéric Thomas es Director de Investigación en el CNRS, laboratorio MIVEGEC (UMR IRD 224-CNRS 5290-Université de Montpellier), Centre national de la recherche scientifique (CNRS)
Este artículo fue publicado originalmente en The Conversation.












